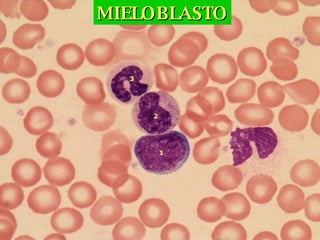
MIELOBLASTO
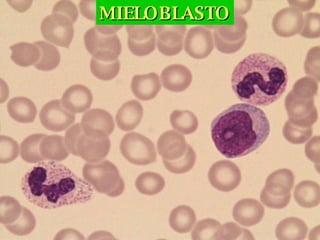
MIELOBLASTO
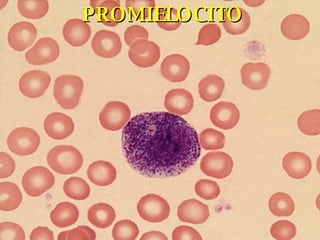
PROMIELOCITO
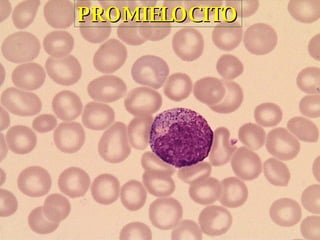
PROMIELOCITO
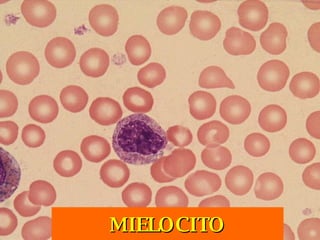
MIELOCITO
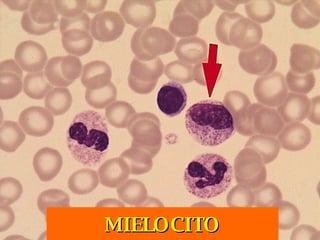
MIELOCITO
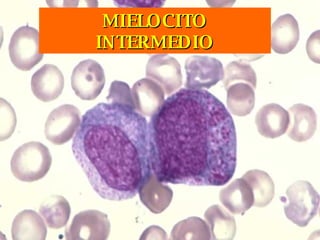
MIELOCITO INTERMEDIO
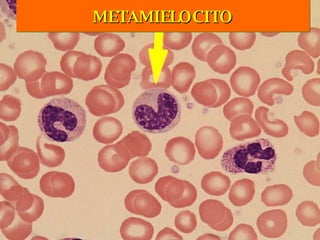
METAMIELOCITO
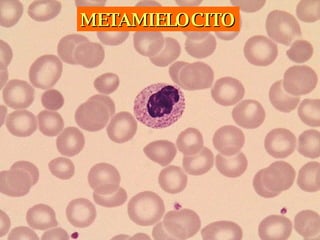
METAMIELOCITO
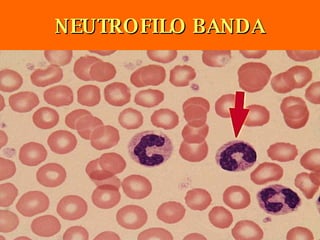
NEUTROFILO BANDA
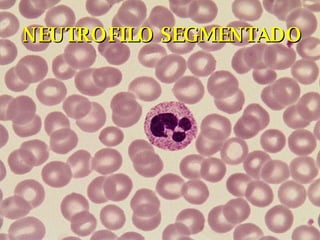
NEUTROFILO SEGMENTADO
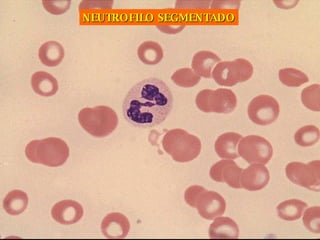
NEUTROFILO SEGMENTADO
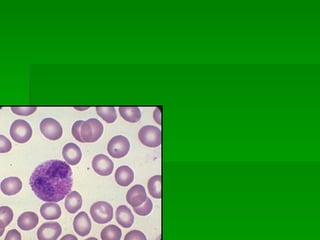
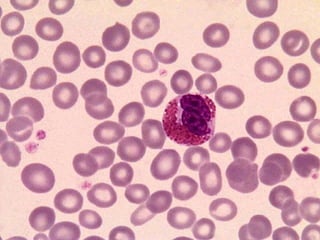
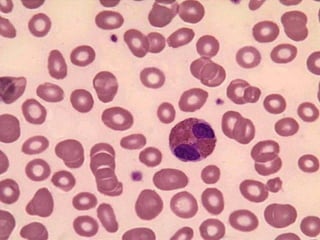
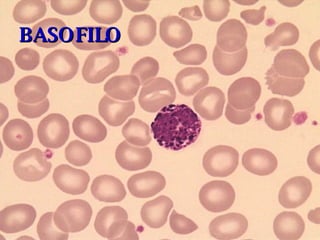
BASOFILO
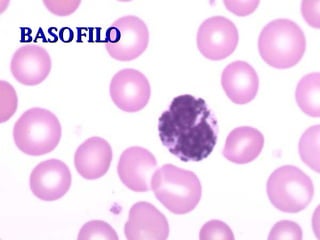
BASOFILO
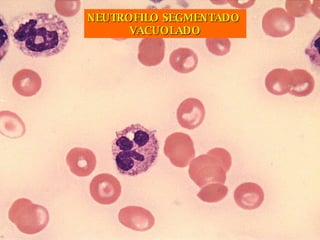
NEUTROFILO SEGMENTADO  VACUOLADO
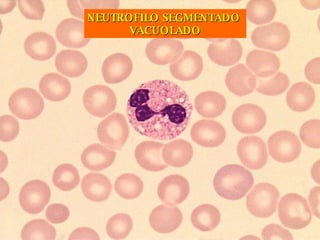
NEUTROFILO SEGMENTADO  VACUOLADO
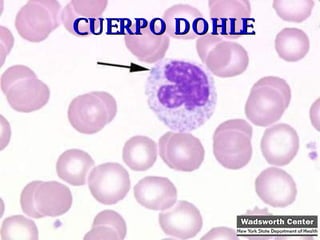
CUERPO DOHLE
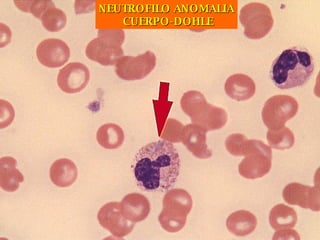
NEUTROFILO ANOMALIA CUERPO-DOHLE
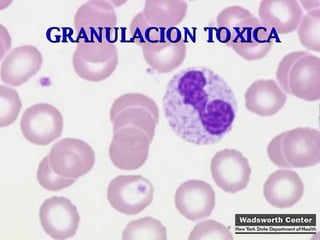
GRANULACION TOXICA
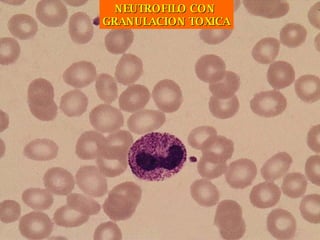
NEUTROFILO CON  GRANULACION TOXICA
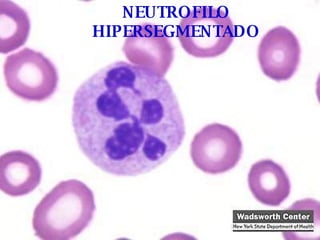
NEUTROFILO HIPERSEGMENTADO
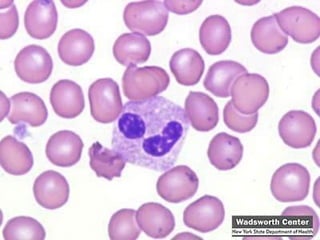
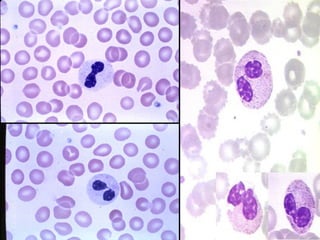
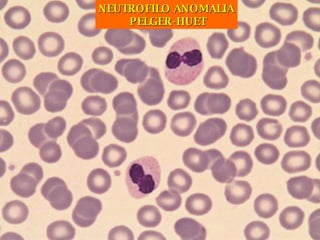
NEUTROFILO ANOMALIA PELGER-HUET
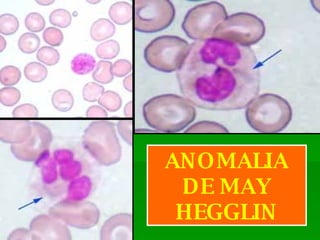
ANOMALIA DE MAY HEGGLIN
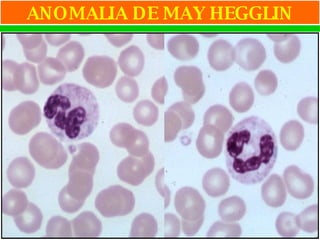
ANOMALIA DE MAY HEGGLIN
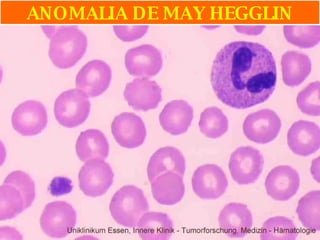
ANOMALIA DE MAY HEGGLIN
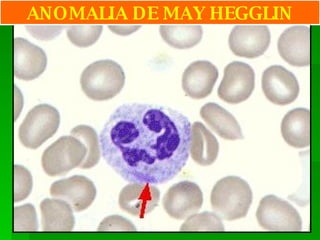
ANOMALIA DE MAY HEGGLIN
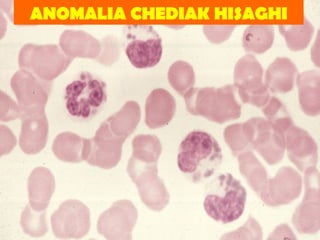
ANOMALIA CHEDIAK HISAGHI
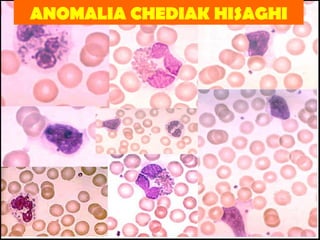
ANOMALIA CHEDIAK HISAGHI
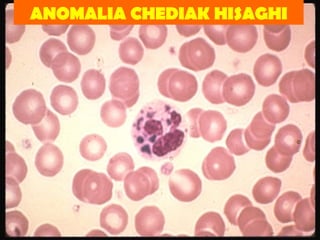
ANOMALIA CHEDIAK HISAGHI
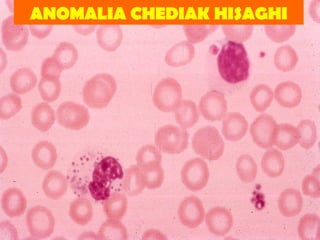
ANOMALIA CHEDIAK HISAGHI
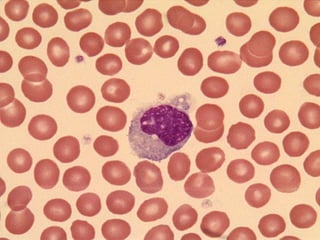
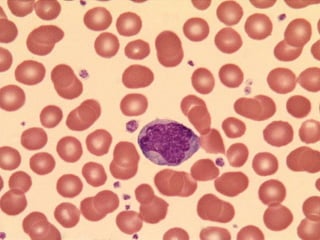
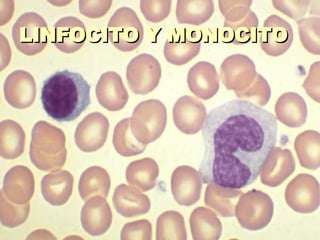
LINFOCITO Y MONOCITO
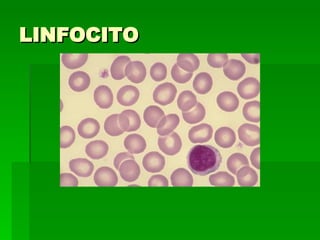
LINFOCITO
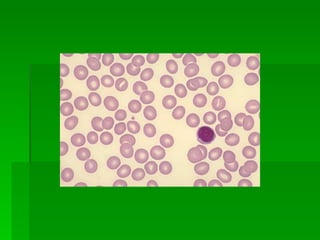
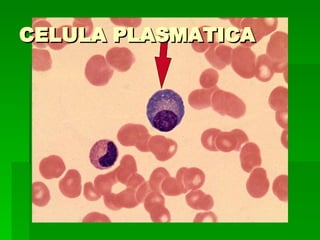
CELULA PLASMATICA
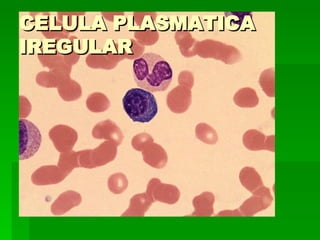
CELULA PLASMATICA IREGULAR
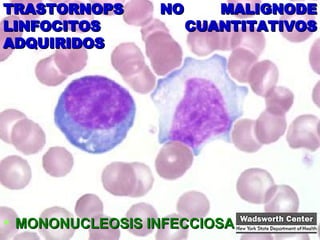
TRASTORNOPS NO MALIGNODE LINFOCITOS CUANTITATIVOS ADQUIRIDOS MONONUCLEOSIS INFECCIOSA
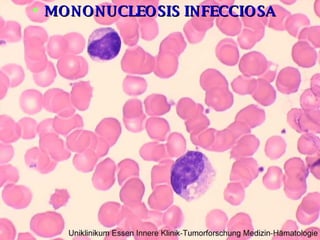
MONONUCLEOSIS INFECCIOSA
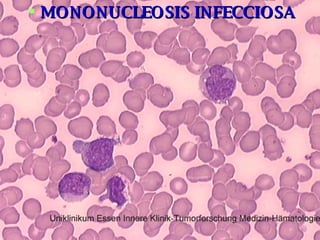
MONONUCLEOSIS INFECCIOSA

Este documento presenta una lista de diferentes tipos de células sanguíneas, incluyendo mieloblastos, promielocitos, mielocitos, neutrófilos, eosinófilos, basófilos y monocitos. También describe varias anomalías y trastornos no malignos que pueden afectar a granulocitos y monocitos, como inclusiones citoplasmáticas, cuerpos de Döhle y anomalías hereditarias cualitativas de los neutrófilos. Finalmente, detalla las etapas de maduración de linfocitos y